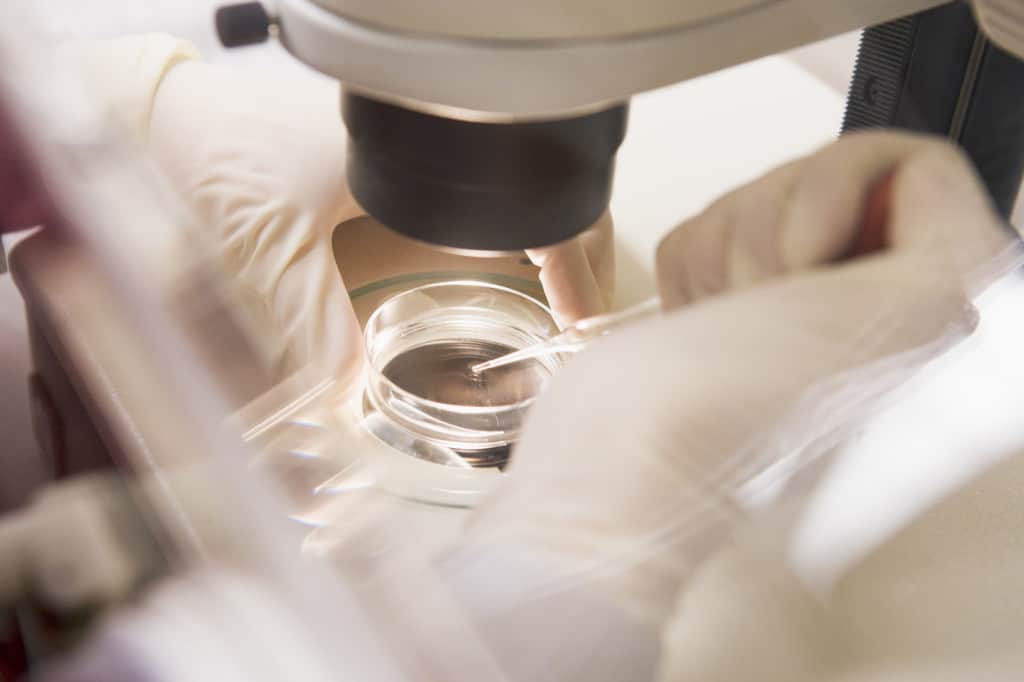
phương pháp hiến tặng trứng 2

Những năm gần đây, phương pháp hiến tặng trứng trở thành giải pháp hiệu quả giúp phụ nữ vô sinh hoàn thiện giấc mơ làm mẹ khi tuổi đã cao và chức năng buồng trứng suy giảm.
Chức năng buồng trứng có thể suy giảm dần theo độ tuổi
Khi đã bước qua độ tuổi sinh sản, chức năng buồng trứng có thể suy giảm dần làm ảnh hưởng không nhỏ đến khả năng làm mẹ của phụ nữ ngoài 40. Thống kê cho thấy hơn 30% phụ nữ không thể mang thai tự nhiên dù chưa bước vào giai đoạn mãn kinh. Ngoài ra, không ít trường hợp phụ nữ không thể mang thai tự nhiên vì quá trình tiêu hủy tế bào trứng diễn ra quá nhanh, khiến nguồn dự trữ trứng bị suy giảm nghiêm trọng. Các bệnh lý buồng trứng cũng là một nguyên nhân khiến thiên chức làm mẹ trở nên xa vời với nhiều chị em.

Phụ nữ vô sinh vẫn có cơ hội làm mẹ nhờ phương pháp hiến tặng trứng
Năm 1984, lần đầu tiên các nhà khoa học thực hiện thành công kỹ thuật thụ tinh ống nghiệm với trứng hiện tặng. Nhờ sự trợ giúp của phương pháp hiến tặng trứng, những người phụ nữ hiếm muộn không thể thụ thai tự nhiên vì buồng trứng suy yếu vẫn có thể mang thai và sinh con. Từ đó đến nay, phương pháp hiến trứng được áp dụng rộng rãi ở các trung tâm hỗ trợ sinh sản trên toàn thế giới, với việc sử dụng cả trứng tươi và trứng đông lạnh.
Sử dụng trứng hiến tặng để thụ tinh ống nghiệm trước khi đưa vào tử cung
Thụ tinh trong ống nghiệm trong hiến tặng trứng
Cả hai phương pháp đều sử dụng trứng hiến tặng để thụ tinh trong ống nghiệm trước khi đưa phôi vào tử cung người nhận. Để tạo thuận lợi cho quá trình hiến trứng, thụ tinh và tạo phôi, người hiến tặng sẽ được chỉ định thuốc kích trứng và người nhận cũng sử dụng thuốc để điều hòa kinh nguyệt với chu kỳ kinh của người hiến trứng. Tuy nhiên, người nhận trứng cần đáp ứng được khả năng sinh sản. Và phương pháp này có thành công hay không còn phụ thuộc rất nhiều vào các yếu tố tuổi tác của người nhận trứng, cũng như trình độ chuyên môn của bác sĩ trong quá trình thực hiện thụ tinh ống nghiệm và nuôi cấy phôi.

Quy trình thụ tinh nhân tạo nhờ trứng hiến tặng
Thiên chức làm mẹ mang đến cho người phụ nữ niềm hạnh phúc lớn lao nhất trong cuộc đời, nhưng vì nhiều lý do mà họ không thể mang nặng đẻ đau và chứng kiến con cất tiếng khóc chào đời. Vì những lý do không mong muốn, hàng ngàn phụ nữ trên thế giới vẫn không thể thụ thai tự nhiên vì chức năng buồng trứng suy giảm. Bởi vậy, hiến trứng là một nghĩa cử nhân văn cao đẹp góp phần tạo nên một mầm sống mới, một niềm hy vọng mới về một gia đình ngập tràn tiếng cười trẻ thơ. Mặt khác, với những phụ nữ đang trong độ tuổi sinh sản mà chưa có kế hoạch sinh con, các chuyên gia sinh sản cũng khuyến cáo việc xem xét trữ đông trứng để đảm bảo khả năng làm mẹ sau này.
Để biết thêm thông tin hoặc đặt lịch thăm khám, tư vấn, điều trị xin vui lòng liên hệ:
Trung tâm IVF Hồng Ngọc – Bệnh viện Đa khoa Hồng Ngọc
Add: Tầng 14, số 55 Yên Ninh, Ba Đình, Hà Nội
Hotline: 0915.960.139 – 0915.330.016
Tel: +(84-24) 3927 5568 ext 6820/6825
Email: arthongngoc@hongngochospital.vn
Xem thêm bài viết:
Những kiến thức cần biết về lạc nội mạc tử cung
Đa nang buồng trứng và những nguy hại
Viêm lộ tuyến và những điều cần biết
English